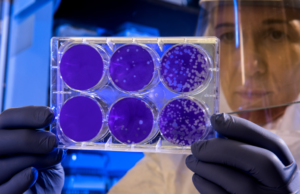
No hay pruebas de que las vacunas estén relacionadas con un exceso de muertes, contrariamente a lo que se afirma en internet Científica evaluando las supuestas muertes por vacuna Covid

Tag: Vacunación
El llamado a detener la vacunación de ARNm contra el COVID-19...
Múltiples estudios muestran que las vacunas contra el COVID-19 han salvado millones de vidas. Recibir las vacunas más recientes proporciona protección adicional contra desenlaces...
Prepublicación de un estudio realizado en Yale registró experiencias de pacientes,...
Compendio SciCheck
La prepublicación de un estudio realizado en Yale describió síntomas crónicos de la vacunación contra el COVID-19 informados voluntariamente por 241 miembros de...
Publicaciones difunden afirmación falsa sobre una solicitud de patente de Moderna
Compendio SciCheck
Las vacunas de ARNm contra el COVID-19, como muchas otras vacunas, pueden contener pequeñas cantidades de ADN procedentes del proceso de fabricación. No...
La vacunación contra el COVID-19 durante el embarazo es segura y...
Compendio SciCheck
Vacunarse contra el COVID-19 ayuda a proteger a las personas embarazadas del COVID-19 grave. Cuando se administran durante el embarazo, las vacunas también...
Las vacunas contra el COVID-19 salvan vidas, no son más letales...
Compendio SciCheck
La vacunación contra el COVID-19 reduce el riesgo de muerte por COVID-19. Algunas publicaciones en las redes sociales han utilizado erróneamente datos de...
No se ha demostrado que las vacunas contra el COVID-19 alteren...
Compendio SciCheck
En las vacunas de ARNm contra el COVID-19 pueden quedar pequeñas cantidades de ADN procedentes del proceso de fabricación. Los pasos de purificación...
Video afirma falsamente que 850 personas murieron de miocarditis en México
Compendio SciCheck
Se han notificado casos de miocarditis después de las vacunas de ARNm contra el COVID-19, pero son muy poco frecuentes y generalmente leves....
Errores en una base de datos dan lugar a afirmaciones falsas...
Compendio SciCheck
La tasa de nuevas infecciones por el VIH en el ejército se ha mantenido relativamente estable desde 2017. Pero publicaciones en redes sociales...
No hay pruebas de que las vacunas estén relacionadas con un...
Compendio SciCheck
Las vacunas contra el COVID-19 reducen sustancialmente el riesgo de morir por COVID-19, y los efectos secundarios graves son muy poco frecuentes. El...
Publicaciones difunden falacias sobre el uso de las vacunas contra el...
Compendio SciCheck
Rusia desarrolló una vacuna contra el COVID-19, Sputnik V, en 2020. El presidente Vladimir Putin ha dicho que recibió tres dosis de la...